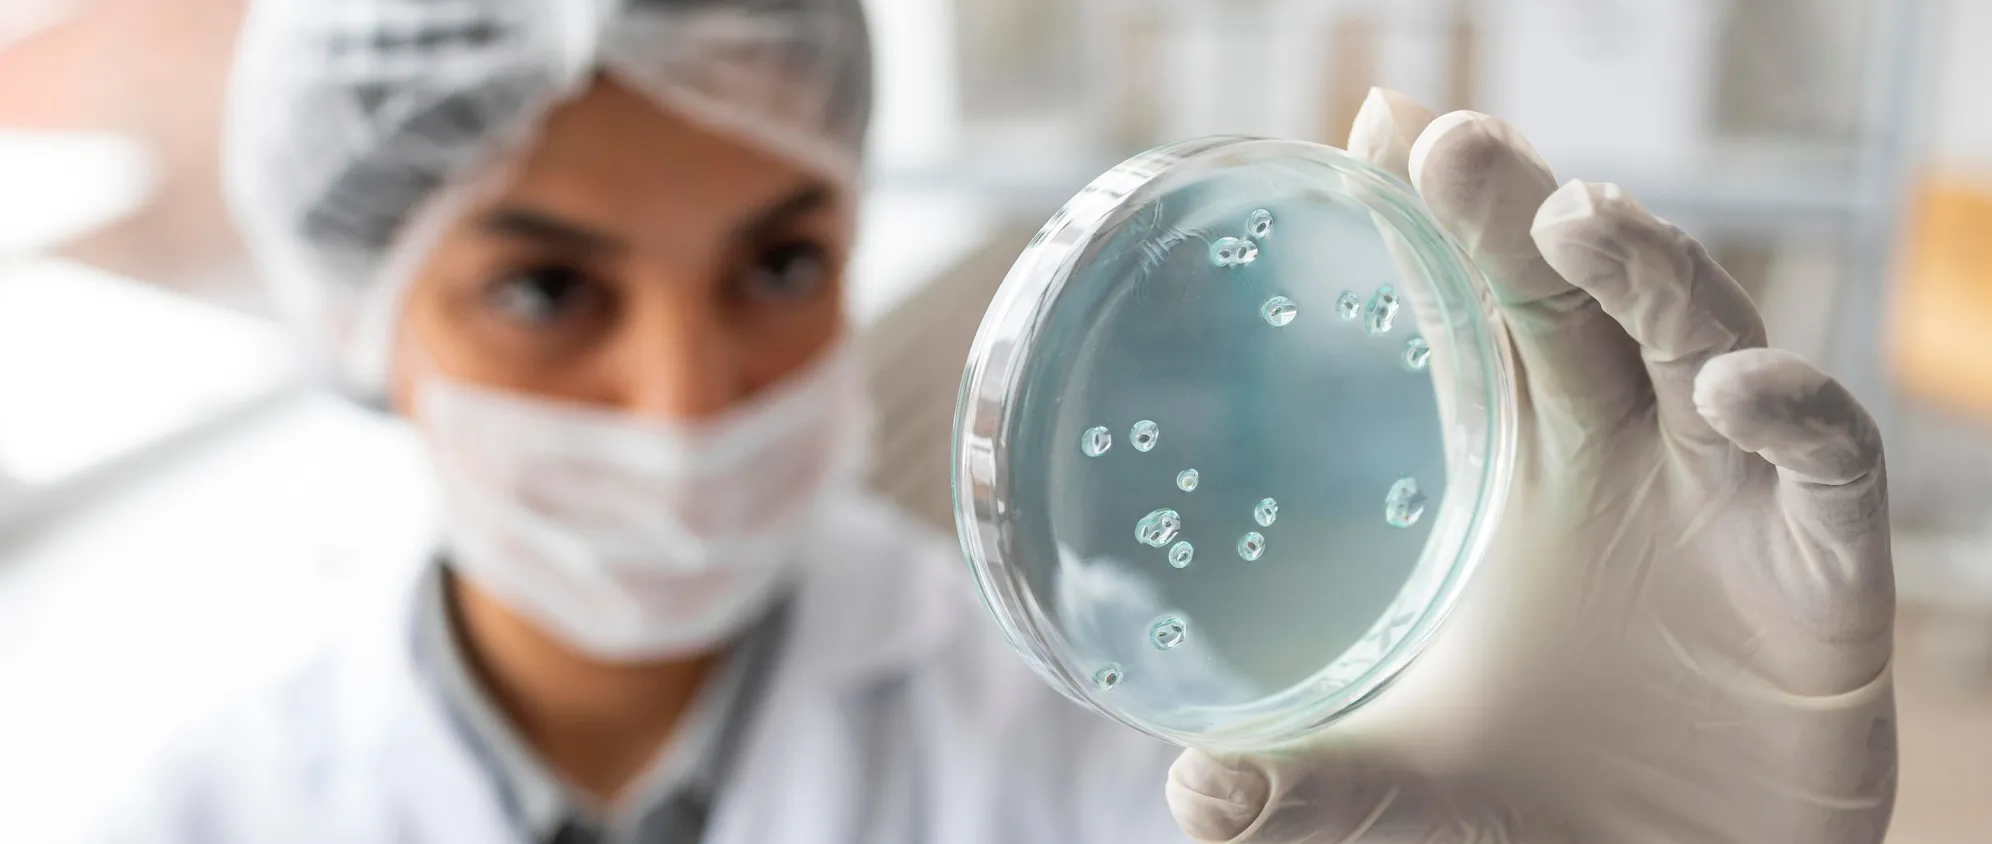

Microbium
About Us
Founded in 2015 in Slovenia, we are experts in microbiology, specializing in the detection and elimination of microbes. Known for our reliability and client-focused approach, we provide tailored solutions across industries.
Our Mission
To enable every company to monitor the microbiological quality of their processes with customized solutions, thereby increasing productivity through time savings, better resource utilization, lower costs, and optimized quality control.
Our Vision
Our vision is to revolutionize environmental and industrial microbiology with sustainable innovations that extend beyond traditional labs. Committed to a healthier, more inclusive world, we collaborate closely with universities and research institutes to drive scientific advancements. With over 100 companies served, we don’t just solve microbiological challenges—we educate, innovate, and transform.
Our Values
We believe in science that delivers real results and in people who drive progress through curiosity and collaboration. Our commitment lies in developing eco-friendly solutions that reduce CO₂ emissions, biocide use, and plastic waste. By digitizing microbiological processes and our internal workflows, we create tools and services that are efficient, transparent, and easy to use.
We prioritize working solutions over paperwork and value early collaboration with clients—often before contracts are signed—because the best ideas emerge through open exchange. Automation is at the core of our approach, helping users save time and make faster, informed decisions.
We place people and relationships above complex systems. By embracing diverse perspectives and adapting roles to individual strengths, we foster a creative and resilient team. We share knowledge freely—with clients, partners, and each other—because a connected community drives meaningful innovation.
All ideas are welcome, as long as they're grounded in thoughtful reasoning. We stay flexible in a fast-changing world and prefer collaborative progress over reinventing what's already been solved.

We Work With
- National institute of Biology
- University of Ljubljana/MariborFaculty of Natural Sciences & engineeringBiotechnical facultyMedical facultyFaculty of Electrical engineering & Computer Science
- Institute Jozef Stefan Ljubljana
- Institute for Chemistry Slovenia
- SPIRIT agency
- And many more
Meet Our Team
Our team is a diverse group of experts united by a shared passion for innovation and excellence in microbiology, water treatment, and technology.

Gregor brings a wealth of expertise and leadership to the company, with a strong background in microbiology, international business, and trading. His deep connections in the microbiological market drive the company’s strategic growth.

Lan leverages his extensive experience in the water treatment sector, gained from a previous start-up, to oversee operations with a focus on efficiency and growth in the water business.

Darjan manages the implementation of public tenders and industry projects, ensuring seamless development of new products and technologies. His environmental microbiology background underpins his strategic approach.

Tilen is an experienced microbiologist specializing in disinfection and product validation to eliminate microbes. He leads our laboratory’s work on industry-focused microbiology projects.

Eva brings her knowledge to our laboratory and helps to tackle most complex analysis and projects.

Rok is the technical mastermind behind the MPN Analyser. A skilled microbiologist, he combines deep technical expertise with a commitment to innovation.